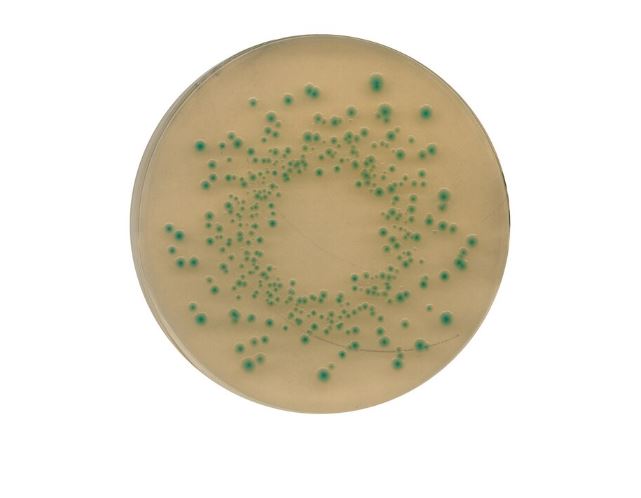

Thông tin cơ bản về Môi trường vi sinh TBX (Tryptone Bile X-glucuronide) Agar
- Xuất xứ sản phẩm: Hãng Merck – Đức
- Mã Code: 1161220500
- Dung tích: Chai nhựa 500g
Thông tin cơ bản về Môi trường vi sinh TBX (Tryptone Bile X-glucuronide) Agar
Thông số về sản phẩm:
- Dạng: chất rắn, màu vàng nhạt đến vàng nâu
- Mã HS 3821 00 00
- Độ hòa tan: 31,6g/lít
- pH 7,0 – 7,4 (36,6 g/l, H₂O, 25 °C) (sau khi hấp tiệt trùng)
- Bảo quản: nhiệt độ +15°C đến +25°C.
- Thời gian ủ: 21 ± 3 giờ ở 44 ± 1 °C hiếu khí
- Tỷ lệ phục hồi 50% tương đương với giá trị năng suất là 0,5.
- Số lượng khuẩn lạc được chỉ định là kết quả của tổng số lần xác định ba lần.
- Môi trường tham chiếu: Tryptic Soy Agar
Ứng dụng Môi trường vi sinh TBX (Tryptone Bile X-glucuronide) Agar
- Dùng chuyên biệt trong PTN để xác định và làm giàu vi khuẩn Escherichia coli trong mẫu thực phẩm, thức ăn chăn nuôi và nước.
- Ứng dụng trong quá trình tổng hợp, phân tích vi sinh tại phòng thí nghiệm trường học, viện nghiên cứu, y tế…
Meta-lab luôn có sẵn Môi trường vi sinh TBX (Tryptone Bile X-glucuronide) Agar thương hiệu Merck, đảm bảo giá cả cạnh tranh và miễn phí giao hàng toàn quốc.
Liên hệ ngay 0789.763.356 để biết thêm thông tin về sản phẩm và nhận báo giá tốt nhất hôm nay.





Đánh giá
Chưa có đánh giá nào.